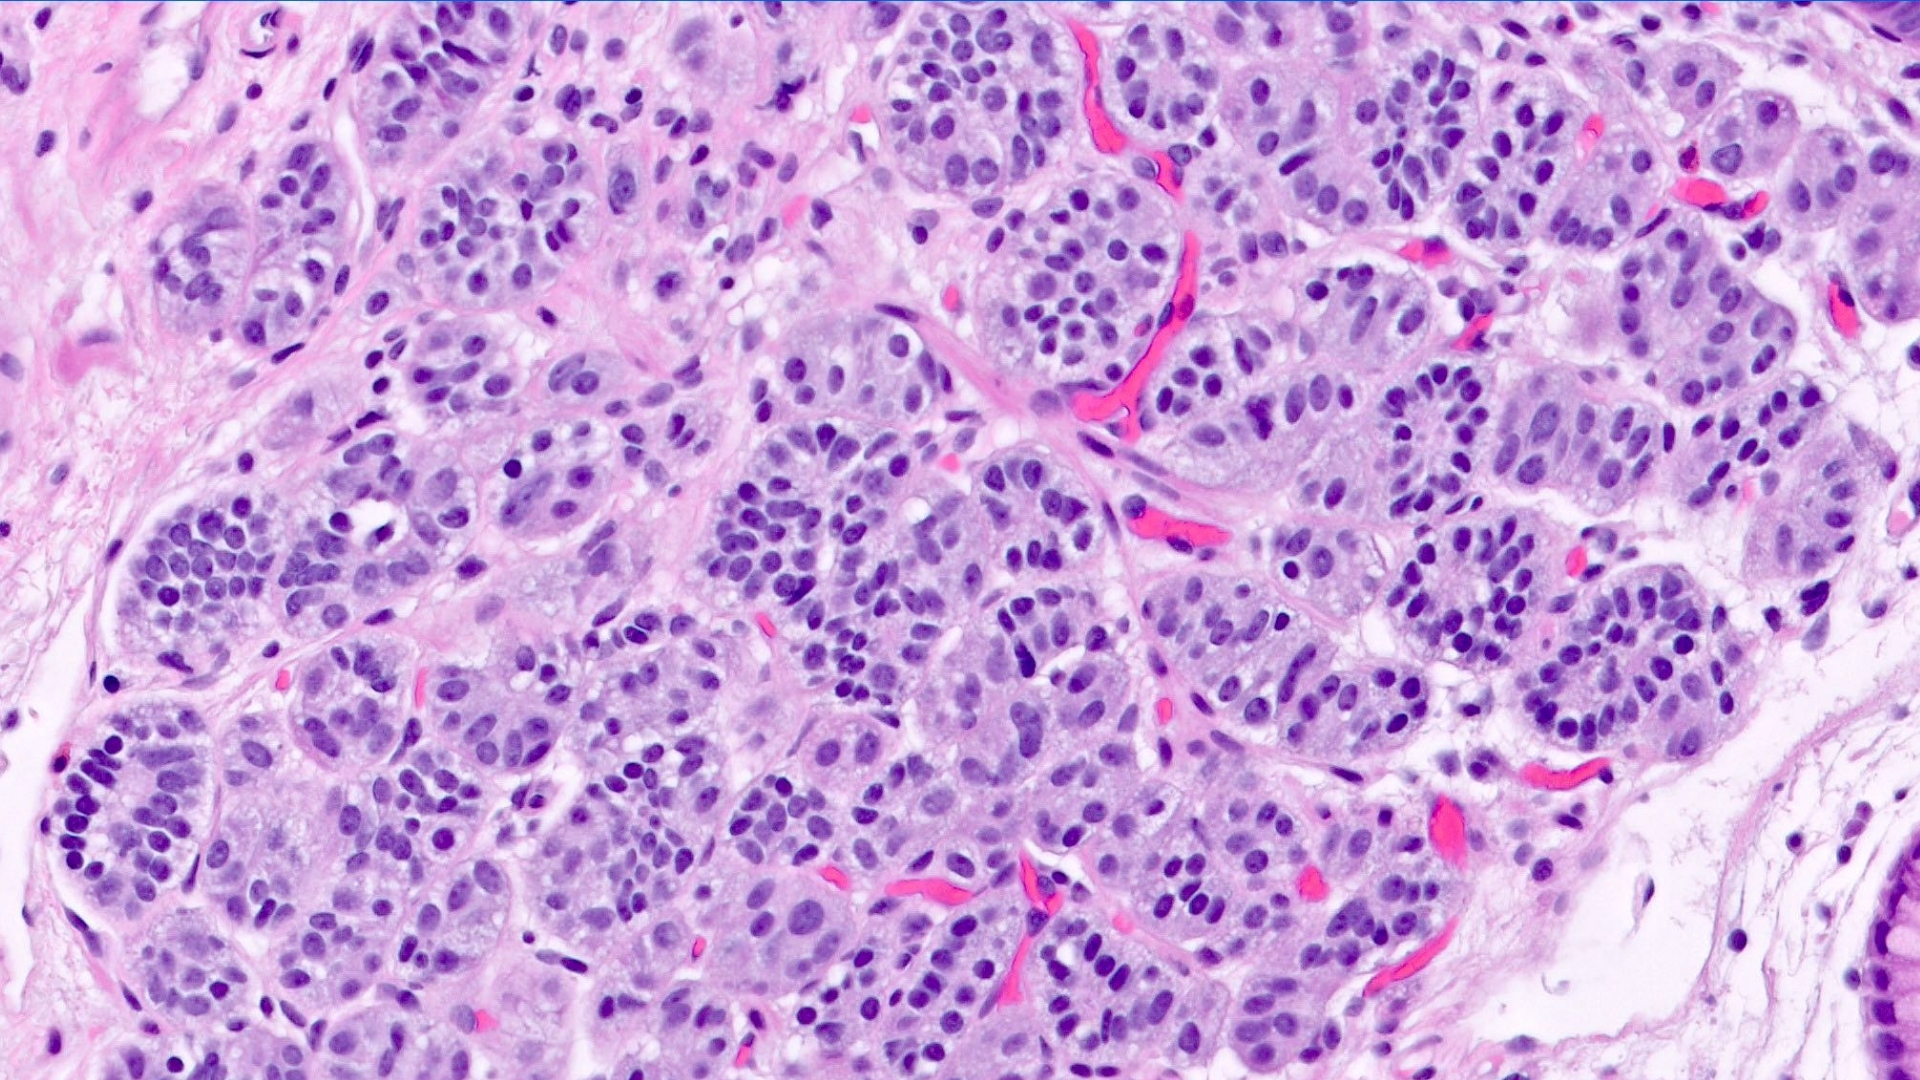

What Is Gastrointestinal Neuroendocrine Tumor (Carcinoid Tumor)?
Gastrointestinal Neuroendocrine Tumor (Carcinoid Tumor) is a unique type of cancer originating from neuroendocrine cells within the gastrointestinal (GI) tract. These vital cells coordinate hormone production, affecting multiple body functions like digestion and metabolism. Unlike conventional cancers, these tumors often grow slowly but depend excessively on glucose metabolism, demonstrating the Warburg effect prominently, where cancer cells consume glucose at approximately 200 times faster than healthy cells. Understanding Gastrointestinal Neuroendocrine Tumor (Carcinoid Tumor) empowers patients and families to manage this condition with optimism and clarity.
Globally, neuroendocrine tumors (NETs) represent approximately 2% of all gastrointestinal malignancies. According to the World Health Organization’s 2024 statistics, these tumors affect around 6 per 100,000 people annually, with rising incidence due to improved awareness and enhanced diagnostics. In Hong Kong and many Asian countries, approximately 15% of gastrointestinal NET cases reveal late-stage presentations due to limited awareness and delayed diagnosis.
Certain patient groups display higher susceptibility, notably adults between the ages of 40 and 60. While Gastrointestinal Neuroendocrine Tumors affect both genders, there’s a slight male predominance (55% male vs. 45% female). Lifestyle factors common in bustling cities like Hong Kong, including dietary habits rich in salted or smoked foods, may further elevate risk.
Biological Basis and Metabolic Vulnerabilities
The hallmark metabolic trait of Gastrointestinal Neuroendocrine Tumors (Carcinoid Tumors) is their significant reliance on aerobic glycolysis, commonly known as the Warburg effect. Cancer cells primarily convert glucose into lactate even with sufficient oxygen available. This metabolic switch allows tumor cells to sustain rapid growth, creating vulnerabilities exploited by cutting-edge metabolic oncology treatments, such as those pioneered by Dr. Li Guohua and Prof. Liu Guolong.
Additionally, neuroendocrine cancer cells frequently exhibit glutamine dependency, using glutamine extensively for nucleotide synthesis and energy production. In fact, approximately 50% of these tumors rely on glutamine pathways, offering therapeutic opportunities for targeted metabolic therapies.
Symptoms and Emotional Impact
Symptoms of Gastrointestinal Neuroendocrine Tumor (Carcinoid Tumor) can vary significantly and often present subtly due to tumor size and activity:
- Abdominal pain and discomfort
- Flushing of the face or neck (Carcinoid syndrome)
- Chronic diarrhea or unexplained weight loss
- Fatigue, due to hormonal imbalances and metabolic disruptions
Diagnosing these symptoms early is crucial due to their physical and psychological toll. Patients often face heightened emotional distress and anxiety related to the diagnosis, emphasizing the importance of compassionate support and accurate information in treatment.
Explore our detailed guide on cancer biology here and modern diagnostic advancements in oncology here.
Causes and Risk Factors of Gastrointestinal Neuroendocrine Tumor (Carcinoid Tumor)
Genetic and Molecular Factors
Genetic alterations significantly influence the development of gastrointestinal neuroendocrine tumors. Common genetic syndromes include:
- Multiple Endocrine Neoplasia type 1 (MEN1): Mutations in the MEN1 gene increase tumor development risk considerably.
- Neurofibromatosis type 1 (NF-1): Linked with increased gastrointestinal NET susceptibility.
- Von Hippel-Lindau disease (VHL): Associated with pancreatic neuroendocrine tumors.
Additionally, somatic mutations and chromosomal alterations such as losses on chromosome 18 contribute significantly to NET pathogenesis.
Environmental and Occupational Influences
Individuals regularly exposed to carcinogenic substances or radiation demonstrate elevated risks for these cancers. In urban Asian regions, including Hong Kong, environmental pollutants significantly contribute to the disease burden. Long-term exposure to chemicals in industrial settings or radiation therapy increases risk insightfully.
Lifestyle and Dietary Factors
Evidence suggests obesity, alcohol consumption, smoking, and dietary patterns significantly affect susceptibility to Gastrointestinal Neuroendocrine Tumors (Carcinoid Tumors). Particularly in Asia, diets high in preserved or smoked foods correlate with elevated cancer incidence.
Metabolic Dependencies of Cancer Cells
Metabolic vulnerabilities play a central role, highlighting the therapeutic exploits of glucose and glutamine dependencies. Dr. Li Guohua’s metabolic oncology strategies, extensively published in Nature Medicine and backed by patents in China, USA, EU, and Japan, specifically target these metabolic pathways, demonstrating significant clinical efficacy in over 12,000 cases.
Asian-Specific Risks and Hong Kong Trends
The local epidemiology in Hong Kong reveals a higher proportion of liver-metastatic NETs, largely due to delayed diagnoses. Hepatitis B prevalence in Asian populations increases susceptibility for liver-origin NETs, emphasizing the significance of early screening and awareness.
Given these insights, early detection through proven screening practices dramatically improves treatment outcomes and life quality. Encourage proactive screenings, embracing a proactive stance towards health and wellness.
Discover how 4D Therapy transforms Gastrointestinal Neuroendocrine Tumor (Carcinoid Tumor) treatment by visiting our innovative treatment strategies here.
Symptoms of Gastrointestinal Neuroendocrine Tumor (Carcinoid Tumor)
Recognizing the symptoms of Gastrointestinal Neuroendocrine Tumor (Carcinoid Tumor) is crucial for early diagnosis and timely intervention. Symptoms can often vary greatly depending upon tumor location, biological behavior, and the individual patient’s overall health condition.
Common General Symptoms:
- Persistent abdominal discomfort or pain
- Unexpected weight loss
- Fatigue and general weakness
- Nausea or vomiting
- Changes in bowel movements (diarrhea or constipation)
- Bloating or gas
- Loss of appetite
Gastrointestinal Neuroendocrine Tumor (Carcinoid Tumor)-Specific Symptoms:
Since carcinoid tumors originate from neuroendocrine cells, they often produce hormones causing distinctive symptoms, collectively known as carcinoid syndrome:
- Facial flushing (redness and warmth)
- Persistent diarrhea sometimes accompanied by abdominal cramps
- Difficulty breathing (bronchospasm)
- Rapid heartbeat (palpitations)
- Skin lesions or rashes
- Pellegra (rough, scaly skin caused by vitamin B3 deficiency)
- Peripheral edema (swelling of legs and ankles)
It is important to note that the expression of symptoms often correlates directly with tumor biology—particularly with the secretion of serotonin and histamine hormones—which are characteristic of this type of neuroendocrine malignancy.
Stage Variation of Symptoms:
- Stage 1-2: Many carcinoid tumors at this early localized stage might show minimal or vague symptoms, making diagnosis challenging without targeted screening or incidental medical tests.
- Stage 3-4: As the disease progresses, hormonally active carcinoid tumors may lead to pronounced carcinoid syndrome symptoms due to increased hormone secretion and metastatic involvement, highlighting the importance of symptom recognition for prompt intervention.
Since symptoms in earlier stages are subtle, individuals experiencing vague digestive discomfort or hormonal symptoms should seek early consultation with specialized oncological teams for comprehensive diagnostics, leading to more favorable outcomes and enhanced chronic management potential.
Stages of Gastrointestinal Neuroendocrine Tumor (Carcinoid Tumor) and Survival Rates
Understanding the staging framework of Gastrointestinal Neuroendocrine Tumor (Carcinoid Tumor) provides vital insight into prognosis and treatment strategies. Here we explore each stage, reflecting survival data particularly relevant to the Hong Kong and wider Asian context.
Stage 1 – Gastrointestinal Neuroendocrine Tumor (Carcinoid Tumor)
Stage 1 tumors are limited to their original site and are generally smaller than 2 centimeters. This stage is marked by limited local growth without lymph node or distant metastases.
- Treatment Options: Surgical excision typically offers definitive therapy, sometimes supplemented by local radiation or ablation techniques to reduce recurrence risk.
- Prognosis/Survival Rates: Patients diagnosed at this stage generally have excellent outcomes, achieving approximately 90-95% five-year survival rates according to recent Hong Kong cancer registry data (2024).
Stage 2 – Gastrointestinal Neuroendocrine Tumor (Carcinoid Tumor)
In Stage 2, the tumor grows beyond the initial site into surrounding tissues but without lymph node involvement or distant metastasis. Tumors at this stage generally measure between 2-4 centimeters.
- Treatment Options: Surgical resection remains primary, often with adjunct radiation or further localized therapy, like endoscopic mucosal resection or minimally invasive techniques.
- Prognosis/Survival Rates: Survival rates remain high around 75-85%, contingent on complete surgical removal, presence of genetic mutations, and secondary preventive strategies.
Stage 3 – Gastrointestinal Neuroendocrine Tumor (Carcinoid Tumor)
Stage 3 carcinoid tumors indicate a more advanced disease state with regional lymph nodes affected. At this juncture, the tumor size may vary, but significant lymphatic involvement means more comprehensive therapeutic strategies are required.
- Treatment Options: Multimodal therapies combining surgery, systemic therapy such as somatostatin analogs, targeted chemotherapy regimens, or peptide receptor radionuclide therapy (PRRT).
- Prognosis/Survival Rates: Approximately 50-70% five-year survival rate, highly dependent on the precise extent and biological aggressiveness evaluated through pathological and molecular profiling aligning with recent Asian-specific clinical research.
Stage 4 – Gastrointestinal Neuroendocrine Tumor (Carcinoid Tumor)
Stage 4 indicates extensive disease with distant metastasis commonly involving critical organs such as the liver, lungs, or bones. Management at this stage shifts toward systemic control and stabilization of symptoms to enhance life quality.
- Treatment Options: Advanced systemic therapies, including FDA-approved somatostatin analogs like octreotide, combined targeted approaches, innovative hormonal modulating treatments, and pivotal metabolic therapeutic interventions leveraging the Warburg effect and glucose metabolism.
- Prognosis/Survival Rates: Survival estimates often indicate variability, typically ranging from 25% to 40% five-year survival, significantly impacted by novel treatment advancements and early integrated metabolic oncology techniques practiced within partnerships like Shenzhen Qianhai Taikang and MD Anderson collaborations.
Recent innovations, such as 4D Therapy and Nobel Prize-winning metabolic oncology advances, are enhancing chronic disease management potential and improving overall quality of life even in advanced stages, emphasizing the shifting paradigm toward stability and chronic care expectations for later-stage diagnoses.
Limitations of Traditional Therapies for Gastrointestinal Neuroendocrine Tumor (Carcinoid Tumor)
Chemotherapy Limitations for Gastrointestinal Neuroendocrine Tumor
Chemotherapy, a widely used conventional treatment for Gastrointestinal Neuroendocrine Tumors (Carcinoid Tumors), significantly varies in effectiveness and poses considerable side effects. Chemotherapy agents primarily target rapidly dividing cancer cells, but often do not effectively differentiate between cancerous and healthy tissues, thus leading to severe systemic toxicities.
Significant Side Effects of Chemotherapy
Common chemotherapy drugs such as cisplatin, carboplatin, 5-fluorouracil, and etoposide induce severe side effects, including:
- Bone marrow suppression, with a risk as high as 78%, resulting in anemia, infections, and increased bleeding tendencies.
- Cardiac toxicity estimated to affect approximately 23% of patients, resulting in serious cardiovascular complications.
- Gastrointestinal side effects such as persistent nausea, vomiting, diarrhea, and mucositis, affecting patient nutrition and quality of life.
- Peripheral neuropathy causing numbness, pain, and debilitating discomfort, negatively impacting patient functionality and mobility.
Moreover, the objective response rate (ORR) in chemotherapy for advanced metastatic Gastrointestinal Neuroendocrine Tumors is alarmingly low, often less than 21%. Patients in the metastatic stage experience limited benefit from chemotherapy, yet must tolerate extensive treatment-related toxicities.
Radiation Therapy Drawbacks for Gastrointestinal Neuroendocrine Tumor
Radiation therapy represents another conventional approach frequently employed for localized and limited metastatic Gastrointestinal Neuroendocrine Tumors. However, radiation yields varying degrees of efficacy combined with substantial limitations and risks, impacting patient outcomes.
Key Issues Associated with Radiation
- Local tissue damage due to radiation exposure, frequently resulting in fibrosis, scarring, and irreversible tissue damage, leading to lasting physical impairments.
- An increased risk of secondary malignancies noted to rise by up to 300% according to the 2023 JAMA Oncology report, considerably increasing complications in long-term patient management.
- Fatigue and psychological distress, reducing patient compliance and complicating successful therapeutic intervention due to treatment discontinuation or dose limitations.
- Technological complexity and reduced accessibility in certain Asian regions, affecting patient access especially in rural or economically constrained settings.
Surgical Approach and Its Risks in Gastrointestinal Neuroendocrine Tumor Management
Surgical excision is primarily recommended for early-stage Gastrointestinal Neuroendocrine Tumors localized within the organ for curative purposes. However, surgical management is hindered in advanced cases due to limitations such as metastasis, invasiveness, and anatomical constraints.
Major Surgical Risks and Limitations
- Infection and postoperative complications, especially for extensive resections, presenting severe risks of systemic infections, delayed wound healing, and prolonged hospital stays.
- Risks of organ failure or critical organ impairment post-resection, particularly relevant when gastrointestinal or hepatic resections predominate.
- Operating risks coupled with lengthy recovery periods, negatively impacting patient quality of life and socioeconomic stability, particularly notable among elderly populations prevalent in Hong Kong and Asia.
- Surgical approaches are futile in many advanced cases—stage IV tumors show limited responsive outcomes, failing to provide optimal disease control with ORR in metastatic states remaining disappointingly low.
Metabolic Resistance in Cancer Cells—A Major Challenge in Conventional Therapies
The rise of drug and treatment resistance significantly hampers traditional therapeutic efficacy, particularly due to cancer cells’ intrinsic metabolic adaptation mechanisms. Cancer cell survival under chemotherapy or radiation exposure often occurs because of upregulated biochemical pathways which protect the tumor microenvironment.
Mechanisms of Metabolic Therapy Resistance
- Cancer cells dramatically enhance glucose metabolism, following the Warburg effect (200-fold increased glucose uptake compared to normal tissue), ensuring survival despite chemotherapy-induced stress.
- DNA repair mechanisms are heightened by approximately 400% compared with healthy tissue, facilitating high resistance to radiation-induced DNA damage and chemotherapeutic agents targeting DNA integrity.
- Increased glutamine dependency and metabolic plasticity, allowing tumor resilience despite typical nutrient deprivation and chemotherapy-induced metabolic stress.
Regional Limitations Specifically in Hong Kong and Asia
In the context of Hong Kong and broader Asia, several regional-specific constraints further compound traditional therapeutic limitations:
- Limited availability and access to advanced radiation and chemotherapy facilities in certain regions, impeding timely patient treatment initiation and management.
- Late-stage diagnosis prevalent in regions with limited healthcare access or substandard screening programs, reducing the viability and efficacy of conventional therapies.
- Increased prevalence of hepatitis B in Asia, indirectly affecting Gastrointestinal Neuroendocrine Tumor prognosis due to compromised liver function, impacting overall outcomes after chemotherapy and surgery.
- Economic barriers limiting patient ability to afford prolonged chemotherapy or postoperative care, amplifying disparities in cancer therapy outcomes among socioeconomic groups.
Conclusion
Traditional therapeutic modalities achieve moderate success in localized early-stage gastrointestinal neuroendocrine tumor management. Nevertheless, their limited effectiveness, significant toxicities, resistance mechanisms, and regional healthcare limitations underscore the necessity for innovative, targeted approaches such as personalized metabolic therapy. Thus, evolving strategies like AllCancer’s pioneering metabolic treatments hold promise by addressing current treatment challenges and improving patient outcomes in Asia and globally.